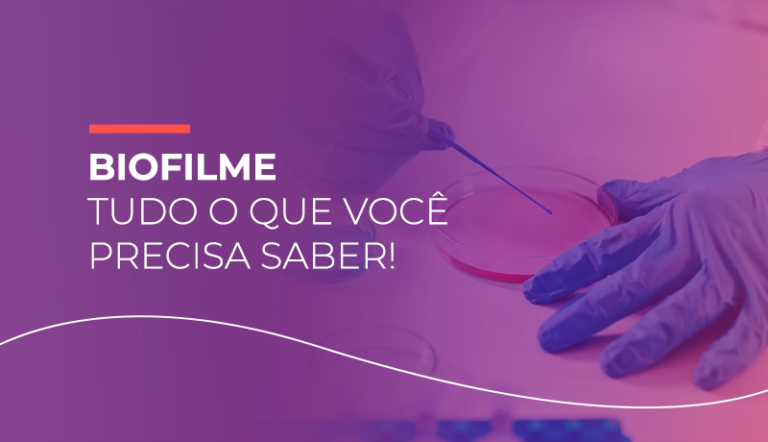
Biofilme

Desvendando o cateterismo vesical intermitente: indicações, durabilidade e contraindicações
Bem-vindo ao universo do cuidado urológico avançado! E em nossa jornada pela saúde, no artigo de

Bem-vindo ao universo do cuidado urológico avançado! E em nossa jornada pela saúde, no artigo de

Muitos aspectos da Epidermólise Bolhosa ainda são desconhecidos pela população. Por isso, nesse artigo, vamos explicar

Você sabe o que são as Úlceras Mistas e o que caracteriza esse tipo de lesão?

Neste miniguia vamos falar sobre um tópico crucial e, também, bastante atual na área da saúde:

A cicatrização de feridas pode ser um processo longo, a depender da gravidade da lesão e diversos fatores podem afetar a cicatrização.
Você sabe o que são os Biofilmes e por que eles são conhecidos como os inimigos

As feridas cirúrgicas são lesões agudas e intencionais, produzidas por um objeto cortante para que seja

No mês de junho, acontece a campanha contra queimaduras, contudo, os cuidados e medidas de prevenção devem perdurar durante todo o ano.

Você sabe o que é a CME? Esse setor, fundamental para os processos em um hospital, foi por muitos anos desmerecido.